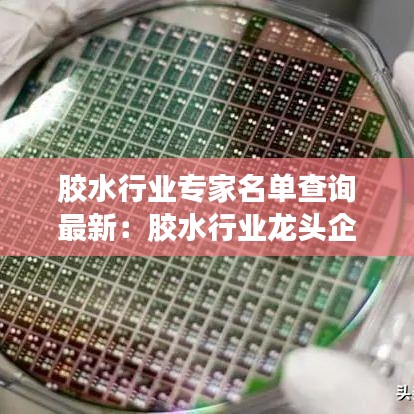
胶水行业专家名单查询最新：胶水行业龙头企业

蔡字笔顺详解,百度带你领略汉字之美
今天我们将一起探讨汉字中“蔡”字的笔顺写法,在汉字书写中,掌握正确的笔顺是非常重要的,它不仅能提高写字效率,还能使字迹更加美观,就让我们一起跟随百度的脚步,探寻蔡字的笔顺奥秘吧。汉字概述汉字是中华民族的文化瑰宝,蕴含...
「独家解析!内蒙呼市必游景点与美食攻略,带你畅游草原之城!」
内蒙古的呼和浩特市,简称呼市,是一座充满历史底蕴与现代气息的城市,这里既有浓厚的草原风情,又有现代化的都市景观,来到呼市,你将被这里的独特魅力所吸引,以下是一份精心策划的呼市旅游攻略,帮助你更好地了解这座城市,充分体...
世界十大危险铁轨排行榜,惊险刺激不容错过!
在世界的各个角落,铁路交通作为重要的交通方式,承载着无数人的出行需求,有些铁轨因其特殊的地理位置、气候条件、历史背景等因素,存在着较高的危险性,以下是世界危险铁轨排名前十名,这些铁轨因其特有的挑战和惊险程度,成为了人...
迪庆今日限号最新消息速递
随着城市化的快速发展,交通拥堵问题愈发严重,为了有效缓解交通压力,各地纷纷采取措施,其中之一便是限号措施,我们聚焦于迪庆地区的最新限号消息,为大家带来相关详情。迪庆地区限号措施背景近年来,迪庆地区的经济快速发展,人口...
全球登机箱销量排行榜TOP榜单揭晓!
随着旅游业的快速发展,登机箱的需求量也在不断增加,在市场上,有许多品牌的登机箱,它们的设计、功能和价格各不相同,在这篇文章中,我们将探讨世界登机箱销量排名,以帮助您了解哪些品牌在市场上最受欢迎。排名前列的登机箱品牌1...
胶水行业专家名单查询最新:胶水行业龙头企业
胶水行业专家名单查询的重要性在胶水行业中,专家名单的查询对于企业、科研机构和投资者来说至关重要。这些专家不仅在胶水研发、生产和技术应用方面具有丰富的经验和深厚的知识,而且在行业发展趋势和市场分析方面也具有独到的见解...
最新款空调官网推荐品牌:空调最新产品
引言:夏季清凉必备,探索最新款空调官网推荐品牌随着夏季的到来,气温逐渐攀升,空调成为了家家户户必备的清凉神器。在这个空调更新换代迅速的时代,如何挑选到性能卓越、品质可靠的空调成为了消费者关注的焦点。本文将为您推荐几...
三合宅自由行指南,精选攻略,轻松畅游
随着人们生活水平的提高和旅游业的繁荣发展,越来越多的人选择在三合宅进行自由行旅游,本文将为您提供一份详尽的01月03日三合宅自由行热门攻略,助您充分准备,尽情享受这次旅行。旅行日程安排第一天(01月03日)上午:1、...
热门书包品牌推荐,选购指南(日期更新)
随着新学期的临近,书包市场逐渐迎来了一年中的销售旺季,本文将为您介绍当前市场上热门的书包品牌,帮助您选购到适合孩子使用的优质书包。品牌概述当前市场上书包品牌众多,竞争激烈,经过市场调研和消费者反馈,以下几个品牌在市场...

沪ICP备2020035651号-1